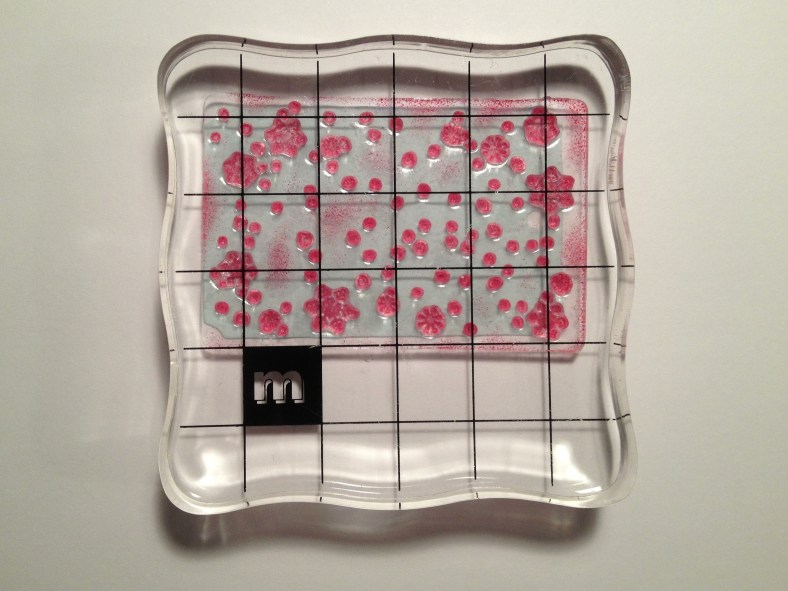
20121220-182036.jpg

I’m going to make a few tags this year. This will be my first go at it, and I intend to keep it simple. I’m writing this post as I make them. Ready?
I bought two stamp sets geared toward tag decorating. At left is the Sending Cheer Decorate It! collection by Hero Arts, which I bought at Target in October. I’ve used the penguin and snowmen on card designs. At right is a Martha Stewart Crafts set, which I bought at T.J. Maxx this week (for $4.99! Score!). The color combination of the ink pads reminds me of my mittens card. They stack and snap together, which I like. The tags in this set are white, light aqua and light green.
First, I’ll make a tag with the Hero Arts set.
Stamp the snowflake image in the silver ink in a random pattern on the tag.

Stamp the “snow much joy” sentiment in the blue ink close to the tag’s top edge and slightly off-center.

Stamp the penguin image in black ink (I used Versafine in onyx black) to the tag’s lower-left portion, keeping the image’s feet off the tag.

Ink the tag’s edges in blue ink.
And now for a tag from the Martha Stewart set:
Stamp the falling snow rectangular image in the red ink onto a light-aqua tag.
Stamp the “HAPPY Holidays!” sentiment in red on one end of a white oval tag.

Adhere the stamped area of the oval tag to the top portion of the aqua tag. Trim off the excess.

Stamp a few snowflake images around the white oval in the light-aqua ink.

Adhere three small light-aqua rhinestones (mine are by TPC Studio) and two small, red pearl-like rhinestones (such as from the Pearl collection by Quern & Co. in berry red) in a random fashion onto the tag. Tie a piece of the red-and-white twine vertically around the tag’s left portion.
This post was brought to you by my iPhone. No, Siri, I said “stamp,” not “stomp.”

